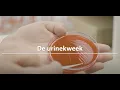
Informatiefilm De Urinekweek

Free
Free
Hoe werkt de Urineweginfectie medische zelftest van Veroval®?
2 minuten en 55 seconden
DOWNLOAD MP3
Download Lagu Uwi Megerikaan Kamu bisa mendownload Lagu secara gratis di Gudanglagump3, Stafaband, Metrolagu & Planetlagu. Untuk melihat detail lagu uwi megerikaan, klik salah satu tombol unduh MP3 yang sesuai, lalu klik tautan DOWNLOAD MP3 uwi megerikaan di halaman berikutnya. Unduh lebih banyak video mp3, 3gp & mp4. Daftar link download Lagu MP3lagu gratis dan streaming gratis full album terbaru.
 Free
Free  Free
Free  Free
Free  Free
Free  Free
Free  Free
Free  Free
Free  Free
Free  Free
Free  Free
Free  Free
Free Free
Free  Free
Free  Free
Free  Free
Free  Free
Free  Free
Free  Free
Free  Free
Free  Free
Free  Free
Free  Free
Free  Free
Free  Free
Free  Free
Free © 2025 Gudang-lagump3.blog download lagu mp3 gratis